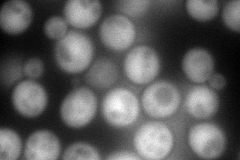
YNL141W
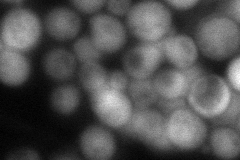
YNL141W
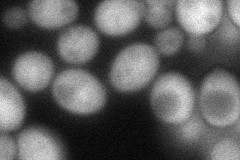
YNL141W
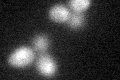
YNL141W

View description
Adenine deaminase (adenine aminohydrolase), converts adenine to hypoxanthine; involved in purine salvage; transcriptionally regulated by nutrient levels and growth phase; Aah1p degraded upon entry into quiescence via SCF and the proteasome
Localization:
Intensity:
Fold change:
Significance:
-
C’ GFP library in SD

below threshold16.94 -
N' NOP1pr-GFP in SD
cytosol193.836 -
N' TEF2pr-mCherry in SD

cytosol244.817 -
N' NATIVEpr-GFP in SD
cytosol84.1722 -
N' TEF2pr-VC and Cyto-VN in SD
cytosol72.5808 -
C’ GFP library in SD+DTT
cytosol15.880.93No -
C’ GFP library in SD+H2O2

cytosol18.351.08No -
C’ GFP library in Starvation Media

cytosol23.281.37No -
C’ GFP library on the background of Pup2-DaMP

below threshold -
C’ GFP library on the background of CCT mutant

below threshold17.15761.01221No
